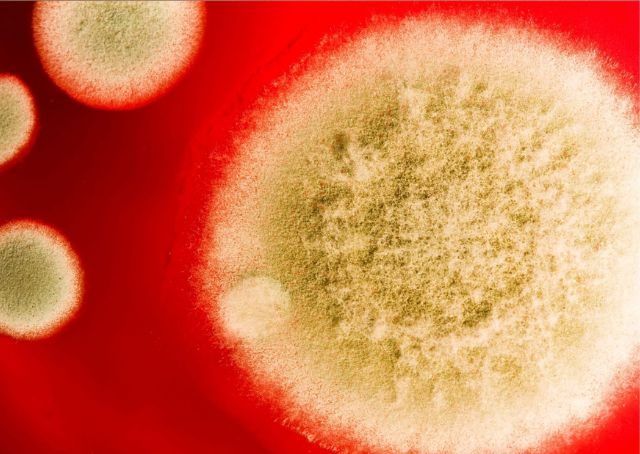
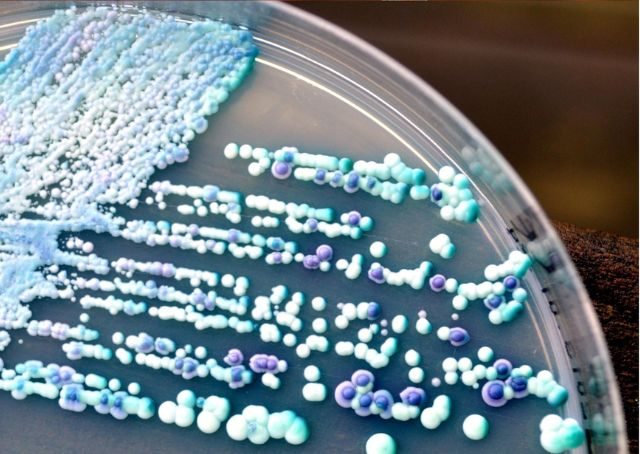

Candida im Darm – harmloser Mitbewohner oder versteckte Ursache für Beschwerden?
Candida – ein verstecktes Problem in deinem Darm?
Hast du schon von Candida albicans gehört? Dieser Pilz ist ein natürlicher Bewohner unseres Darms – doch wenn er sich unkontrolliert vermehrt, kann das unangenehme Folgen haben.
Verdauungsprobleme, Müdigkeit, Heißhunger auf Süßes? All das kann mit einer Candida-Überwucherung zusammenhängen. In diesem Artikel erfährst du, woran du erkennst, ob Candida bei dir zum Problem geworden ist – und was du dagegen tun kannst.
Diesen Blog-Artikel schreibe ich, angestoßen durch einen Patienten-Termin in der letzten Woche. Ich habe etwas zum Thema Candida recherchiert und möchte es in diesem Rahmen gerne teilen.
Candida - Diagnostizieren ist die Herausforderung!
Vielleicht wurde bei Dir Candida im Stuhl festgestellt? (Gar nicht so einfach. Denn oft gedeiht Candida im Bio-Film. Der Biofilm sitzt fest an der Darmwand und geht selten mit dem Stuhl ab.)
Oder reagiert sogar schon Dein Immunsystem auf eine Candida-Infektion?Dies ist leicht über einen IgG-Wert nachweisbar. Ein Bluttest gibt da Gewissheit.
Candida - die Ursache vieler Gesundheitsstörungen.
Warum ist Candida albicans bei den entsprechenden Beschwerden so selten auf dem Schirm? Warum kontrolliert Dein Arzt das bei entsprechenden Symptomen nicht? Ganz einfach - weil zu wenig darüber bekannt ist.
Mir ist im Laufe meiner Praxisjahre Candida schon häufig über den Weg gelaufen. Allerdings maskiert.
Candida - Maskierte Beschwerden.
Maskiert wirst Du fragen? Was heißt das? Maskiert, weil die Symptome des Patienten nicht klar einer Candida-Besiedelung zuzuordnen waren. Die Beschwerden waren meist nicht wirklich greifbar, diffus. Und chronisch.
Über längere Zeit waren Beschwerden da, die sich nicht wirklich behandeln ließen. Trotz verschiedener, guter therapeutischer Maßnahmen. Wenn das bei Dir auch der Fall ist, dann lass uns mit dem Thema Candida beschäftigen.
Vielleicht erkennst Du Dich in den folgenden Symptomen wieder?

Candida albicans kann eine Menge Symptome machen
- Blähungen, Druckgefühl, aufgeblähter Bauch
- Bauchkrämpfe, Bauchschmerz
- häufige Durchfälle im Wechsel mit Verstopfung,
- Stuhlkonsistenz meist schmierig oder dünnflüssig
- Blähungen als Symptom besonders nach dem Essen von Süßigkeiten,
- Obstsaft und Kohlenhydraten, zum Teil sehr übel riechend
- Belag auf der Zunge (typisches Muster)

- Soor oder Windeldermatitis bei Kindern
- Juckreiz am Darmausgang (Häufig wird dabei nur an Würmer, aber nicht an einen Darmpilz gedacht. Gerade bei Kindern, eine Überlegung wert...)

- Scheidenpilz, Scheideninfektionen, Ausfluss,
- wiederholte Blasenentzündungen oder Blasenreizungen
- Heißhungerattacken auf Süß (Der Pilz will Futter...)
- Übergewicht oder Schwierigkeiten abzunehmen
- Hautprobleme: Neurodermitis, Ekzeme, akne-artiger Ausschlag

- nicht heilende Stellen im Bereich des BH-Bügels
- wiederkehrende Entzündungen in unterschiedlichen Körperbereichen
- Leistungsschwäche, chronische Müdigkeit
- Infektanfälligkeit
- erhöhte Leberwerte ohne erkennbare Ursache (wegen der Pilz-Toxine)
- später eventuell die Entwicklung einer Fettleber und Leberschäden
Nur das Symptom zu behandeln, wird dein Problem auf Dauer nicht lösen. Es gilt an der Ursache zu arbeiten und den Faktor zu beseitigen, der jeglichen Therapieerfolg immer wieder zunichte macht. Den Candida.
Pilze - Nützlich.
Jetzt bist Du wahrscheinlich erstmal geschockt und sagst: Pilze - Oh Nein!!! Doch Pilze sind nicht gleich Pilze!

Zur Gattung der Pilze gehören ca. 100.000 bekannte Arten. Einige davon sind für uns Menschen nützlich. Wir genießen sie als Speisepilze. Nutzen Pilze in der Käseherstellung und in Bierhefe oder Backhefe.
Pilze zersetzen Deinen Komposthaufen im Garten und lassen fruchtbaren Boden entstehen.
Pilze - Lästig.
Es gibt einige Arten von Pilzen, die für uns Menschen mehr oder weniger schädlich sind. Dazu zählt auch der oft unterschätzte Aspergillus niger, ein Schimmelpilz im Badezimmer oder Kellerbereich. Oder Rhodotorula, eine rosa rötliche Hefe, die sich an Duschvorhängen, auf Fliesen oder an Silikonfugen festsetzen kann. Doch auch da ist nicht jeder Schimmel der gleiche Schimmel. Manche Schimmelarten sind leicht entfernbar und relativ harmlos.
Andere wiederum verbreiten Sporen, die Dein Atmungssystem irritieren können. Reizhusten oder Allergien auslösen können. Immer, wenn du in die Nähe kommst, den betroffenen Raum betrittst. Hier lohnt es sich definitiv, einen Fachmann zu konsultieren.
Pilze - Schädlich. Gesundheitsschädlich!!!
In Deinem Körper können Pilze großen Schaden anrichten. Es gibt 3 große Gruppen von schädlichen/gesundheitsschädlichen Pilzen im menschlichen Körper.
1) Schimmelpilze - Aspergillosen in den Atemwegen, den Nebenhöhlen, den Bronchien, oder gar der Lunge

Gerade Aspergillus fumigatus kommt überall in der Umwelt vor, besonders in feuchten oder verrottenden organischen Materialien wie Kompost, Erde oder Klimaanlagen. Es ist auch der klassische Pilz, wenn Hauswände und Kellerräume von Schimmel befallen sind.

Beim Einatmen dieser Pilzsporen können sie in die oberen Atemwege gelangen und die Lunge befallen. Eine Aspergillose kann harmlos verlaufen. Aber bei geschwächtem Immunsystem oder bei älteren Patienten können diese Schimmelpilze zu schweren Komplikationen führen.
2) Hautpilze - Dermatophyten

Der Nagelpilz (Onychomykose) gehört zur Gruppe der Hautpilze. Er wird meist durch dieselben Erreger verursacht, die auch Fußpilz oder andere Hautpilzinfektionen auslösen, insbesondere durch Dermatophyten wie Trichophyton rubrum. Diese Pilze befallen die Nägel, indem sie das Keratin abbauen, das die Nagelsubstanz bildet.
3) Hefepilze (Candida albicans gehört zu dieser Gruppe)
Besonders die Hefepilze bereiten im Darm Schwierigkeiten. Da ihr Stoffwechsel Gärung bedingt. Und das ist spürbar und riechbar. Die Symptome habe ich oben schon aufgezählt.
In meinen Ausführungen möchte ich mich auf diese Kategorie beschränken. Wenn ich Candida sage, meine ich hier im Artikel den Hefepilz Candida albicans im Darm.
Candida - Henne oder Ei?
Ein zu viel von Pilzen im Darm ist immer als Symptom zu verstehen. Etwas ist nicht in Ordnung. Etwas hat das empfindliche Gleichgewicht gestört. Der Candida - ein Pilz - wuchert im Darm.
Das ist ähnlich wie bei Pilzen draußen in der Natur. Pilzen, die auf alten, verrotteten Baumstämmen wachsen. Diese Pilze können dort gedeihen, weil Teile des Baumes nicht mehr gesund sind, unter Umständen schon abgestorben. Ähnlich ist es auch beim lebenden Organismus. Der Pilz fasst Fuß, weil irgendetwas im Körper nicht stimmt.

Aus meiner Sicht gibt es 3 hauptsächliche Faktoren, die eine Pilzüberwucherung im Darm begünstigen:
- Die normale Flora im Darm ist gestört oder geschwächt nach einer Antibiotikaeinnahme zum Beispiel oder wenn du unter Dauerstress stehst.
- Das körpereigene Immunsystem hat nicht mehr genug Schlagkraft, um die Pilze abzutöten oder unter Kontrolle zu halten. Weil Du vielleicht schon eine ganze Weile schlapp und energielos bist.
- Ein Überangebot an Kohlenhydraten: Hier meine ich ein zu viel an Zucker und süßen Lebensmitteln, Süßigkeiten, Keksen, Kuchen, aber auch ein zu viel an Brot und Nudeln. Auch der übermäßige Genuss von süßem Obst, Trockenfrüchten, Säften oder Smoothies kann die Pilzvermehrung fördern.
Daneben stehen die vielen Risikofaktoren, die eine Pilzüberwucherung im Darm fördern. Erkennst Du das eine oder andere wieder?
Candida - Risikofaktoren:
Das ist mal meine Auflistung, die aber keinen Anspruch auf Vollständigkeit erhebt.
Candida - Risikofaktor - Medikamente:
- Antibiotika-Einnahme
- immunsuppressive Medikamente
- Antidepressiva: langsame Darmpassage
- Pillen-Einnahme!!!

Candida - Risikofaktor - chronische Erkrankung:
- geschwächte und abwehrgeschwächte Personen,
- Patienten mit Krebs, HIV,
- Diabetes Patienten (das mit dem Zucker funktioniert nicht, wie es soll)
- bei langanhaltenden Infektionserkrankungen
- Dialyse-Patienten
Candida - Risikofaktor - Verdauungsstörung:
Die gegessene Nahrung liegt zu lange unverdaut im Darm. Es gärt und gammelt. Die Pilze können sich in diesem Millieu richtig gut einnisten und vermehren.
In diesem Zusammenhang haben wir es auch häufig mit dem Phänomen Bio-Film zu tun. Die perfekte "Wohnumgebung" für einen Candida albicans.
Candida - Risikofaktor – Schwermetall-Belastung:
Schwermetalle im Darm erleichtert es dem Candida, Fuß zu fassen. Quecksilber, Blei oder Cadmium können das Gleichgewicht der Darmflora stören und so das Immunsystem schwächen. Dies schafft günstige Bedingungen für das Wachstum von Candida und begünstigt dessen Überwucherung im Darm.
Im Fall von Candida und Schwermetallen könnte es sich um eine „Zweck-Gemeinschaft“ handeln. Der Pilz bindet die Schwermetalle und damit schützt er sowohl sich selbst als auch den Wirt vor der toxischen Wirkung der Schwermetalle.
Achtung: Beim Absterben vom Candida werden dann auch vermehrt Schwermetalle frei. Und: Bei einer Schwermetallentgiftung z. B über Chelatieren kann es zu einem Candida-Schub kommen.
Candida - Risikofaktor - Zahnprobleme:
Probleme mit den Zähnen oder dem Gebiss bedingen zweifelsohne den Punkt Verdauungsstörung. Und sie bedienen oft auch den Punkt Schwermetall-Belastung. Ich denke da an metallische Überkronung, Brückenversorgung oder gar Amalgamfüllungen.

Wenn Du aufgrund deiner Zähne nicht gut kauen kannst, landet viel unverdaut im Magen-Darm-Trakt und gärt dort vor sich hin. Neben Blähungen und Völlegefühl kann das auch die Entstehung eines Darmpilzes begünstigen.
Candida - Risikofaktor - hormonelle Umstellungsphase:
Schwangerschaft, Geburt, Menopause
Candida - Risikofaktor - Stress:
- Cortisol, unser Dauerstresshormon, verändert den Blutzuckerspiegel
- Stress beeinträchtigt über den Sympathikus unseren Magen-Darm-Trakt, eine Mangeldurchblutung des Darm oder auch ein reihenweises Absterben der Laktobazillen kann daraus folgen – Dysbiose
- Stress verführt dazu, ungesunder und stresskompensierend zu essen – viel süss – das liebt der Pilz
Wie du siehst, gibt es einige Faktoren, die dafür prädestinieren, sich einen Candida einzufangen.
Nur eine gesunde intakte Darmflora kann die Ausbreitung von Pilzen und schädlichen Keimen verhindern!
Die Darmflora - das ist die 3. Schicht unserer schleimhautbasierten Abwehr - beinhaltet die "guten" Darmbakterien, die unsere Schleimhäute besiedeln und von denen wir auch profitieren. Sie wehren schädliche Reize ab und verhindern, dass sich schadhafte Bakterien wie z.B. Clostridien oder auch Pilze unkontrolliert ausbreiten. Wir Erwachsene haben bis zu 1,5 kg Darmbakterien in den unzähligen Windungen von Dünn- und Dickdarm. Diese guten Keime sind zum Teil in der Lage, bakterienhemmende, pilzhemmende oder auch bakterienabtötende Substanzen zu bilden, die die für uns schädlichen Keime eindämmen.

Damit es diesen "guten" Darmbakterien gut geht und sie sich munter vermehren können, brauchen sie das richtige Umfeld (einen entsprechenden pH-Wert) und auch das richtige Futter (Hier denke ich besonders an Ballastoffe und an das Butyrat... → Mehr dazu beim Thema: Darmsanierung/Darmaufbau...)
Candida ist nur ein Symptom!
Ein vermehrter Pilzbefall des Darms ist keine eigenständige Erkrankung, sondern eher ein ernst zunehmendes Symptom. Und deshalb auch nicht einfach mit einem Mittel auf Rezept zu behandeln. Wenn Du unter einer Candida-Infektion leidest, solltest Du auch folgende Punkte auf dem Schirm haben:
- Wie stärke ich meine normale Darmflora?
- Was kann ich tun, um mein Immunsystem zu stabilisieren?
- Wie muss ich mich ernähren, um meine Darmflora stabil zu halten?
- Gibt es noch zusätzliche unterstützende Maßnahmen?
Gerne unterstütze ich Dich mit meinem Erfahrungsschatz aus mehr als 25 Jahren naturheilkundlicher Darmbehandlung. Vereinbare einfach einen Termin, und wir schauen, wie wir Deine Beschwerden lindern/beseitigen.
Jetzt widmen wir uns der Frage: Was tun bei Candida? Denn wenn Du betroffen bist, machst Du Dir vielleicht Gedanken darüber, was Du selbst tun kannst, um Deine Beschwerden zu lindern.
Candida - Was tun???
Die Behandlung eines Darmpilzes erfordert Geduld und konsequentes Umsetzen der einzelnen Behandlungsschritte. Nur so ist ein Erfolg erreichbar. Du kannst keine Stufe überspringen oder beschleunigen, was wichtig ist: Bleibe dran!
Bleibe bitte dran! Gerne berate ich dich, was in deinem Fall ein sinnvolles Vorgehen ist.
➡️ Beratungstermin vereinbaren:
1) Candida - Anti-Pilz-Diät
Jetzt wirst Du Dich sicherlich fragen, was Du essen kannst, damit Du
diese lästigen Mitbewohner in Deinem Darm nicht noch zusätzlich
fütterst. Hier ein paar Anhaltspunkte.

Wenn Du die komplette Liste haben möchtest oder eine begleitende Beratung wünschst, fordere das hier entsprechend an: Stichwort: Anti-Pilz-Diät ... anfordern
- Verzichte auf alle zuckerhaltigen Lebensmittel, Süßigkeiten, Süßspeisen wie Kuchen, Kekse, Pudding, Schokolade, Eis, Nuss-Nougat-Cremes
- Hierzu gehören auch die alternativen Süßungsmittel wie: Ursüße, Vollrohrzucker, Honig, Zuckerrübensirup, Ahornsirup, Honig oder Melasse. Meide auch Marmeladen, Fruchtgelees, Trockenfrüchte, Fruchtsaucen.
- Süßes Obst nährt den Pilz, deshalb nur auf saures Obst (z.B. Beerenfrüchte... ) zurückgreifen
- Lass bitte die Finger von zuckerhaltigen Getränken wie Softdrinks, Limonaden, Cola, Fruchtsäften und Smoothies.
- Meide für die Kur-Zeit jegliche Art von Alkohol (Der wird direkt zu Glukose = Zucker verstoffwechselt und füttert direkt die Pilze...)
- Meide Kohlenhydrate: Hier besonders Weißmehlprodukte wie Brot und Nudeln, aber auch weißen Reis.
- Vermeide alle Produkte, welche Hefe enthalten. (Du hast einen Hefepilz...)
- Ketchup, Majo, Senf, Fertigdressings oder Soßen sollten für Dich Tabu sein
- Meide Fertigprodukte!
- Iss leicht, damit die Nahrung nicht zu lange in Deinem Magen-Darm-Trakt verbleibt und dem Candida die Möglichkeiten gibt, sich wieder festzusetzen.
2) Candida - Abtöten der Pilze
Zu Beginn ist es wichtig, die Menge der vorhanden Candida einzuschränken. Wichtig ist in jedem Fall die Ernährungsumstellung. Je nach Befund wähle ich die weiteren Behandlungsmethoden aus.
Allgemein bekannt ist das Medikament Nystatin, welches auch häufig als erste Wahl angewandt wird. Dazu kann ich nicht immer raten, denn wie immer: Keine Wirkung ohne Nebenwirkung! Auch hierbei es gilt therapeutisch immer ganz genau abzuschätzen, ob dieser Weg angezeigt ist.
Nystatin empfehle ich nur bei schwerer und schon länger andauernder Belastung mit Candida, bei hohem Leidensdruck, nur wenn die Patienten sonst gesundheitlich stabil sind und unter strenger therapeutischer Begleitung. Bitte keine Alleingänge hier!
Wieso? Wenn schnell größere Mengen an Hefepilzen absterben, kann es leicht zur Überforderung Deines Körpers kommen. Große Mengen an toten Pilz-Zellen müssen schnell aus dem Darm abtransportiert werden. Diese toten Zellen produzieren jede Menge Stoffwechselendprodukte, welche toxisch wirken können.

Wie spürst Du das? Nach Einnahme der Mittel verschlimmern sich Deine Symptome. Es kann zusätzlich zu Fieberschüben, Übelkeit, Muskel- und Gelenkschmerzen oder Kopfschmerzen kommen. Dies geschieht im Rahmen der sogenannten Jarisch-Herxheimer-Reaktion. Das fühlt sich definitiv nicht gut an, ist aber ein Zeichen dafür, das etwas in Bewegung kommt.
Wie zeigt sich die Jarisch-Herxheimer-Reaktion im dem Zusammenhang?
Die Symptome setzen meist innerhalb weniger Stunden nach Beginn der Therapie ein und können unterschiedlich stark ausfallen. Sie reichen von Kopfschmerzen, Muskelschmerzen, Gelenkschmerzen über Übelkeit, Müdigkeit, Schwindel bis hin zu Fieber und starkem Krankheitsgefühl.
Nicht wundern: Es kann auch zu einer temporären Verschlechterung deiner Grundsymptomatik kommen. An der Oberfläche reagiert dein Körper vielleicht mit Juckreiz, Rötung oder sogar Bläschenbildung.
Diese Symptome sind in der Regel nicht gefährlich, können aber belastend sein, besonders wenn du sie nicht einordnen kannst. (Merke: Die Jarisch-Herxheimer-Reaktion tritt auch oft in Zusammenhang mit Borrelien auf.)
Warum tritt die Herxheimer-Reaktion im Zusammenhang mit Candida auf?
Wenn Candida abstirbt, werden große Mengen toxischer Stoffe freigesetzt.
Dazu gehören Endotoxine (Teile aus Bakterienwänden) – LPS; entzündungsvermittelnde Stoffe (u.U. Histamin), die dein Immunsystem zusätzlich triggern können, und natürlich auch Zellabfall aus dem Candida.
On Top: Der absterbende Candida setzt gebundene Schwermetalle frei. Jetzt wird dir wahrscheinlich klar, warum sich das gerade alles so mies anfühlt.
Eine gute Nachricht:
Die Symptome halten in der Regel nur einige Stunden bis wenige Tage an. In schweren Fällen kann es auch bis zu einer Woche dauern. Die Intensität variiert je nach individueller Entgiftungskapazität (da spielt deine Genetik mit rein). Aus diesem Grund rate ich davon ab, diesen Schritt ohne fachgerechte Begleitung zu gehen. Gerne unterstütze ich Dich dabei, den Candida loszuwerden. Lass Dich bitte dazu von mir vorher beraten.
Gerade bei Kindern und zur langsamen Therapie bei Vorerkrankungen ist zum Abtöten des Candida ein spezieller Extrakt aus Olivenblättern mein Favorit. Beide Behandlungsmöglichkeiten (Nystatin und Olivenblattextrakt) können auch gut miteinander kombiniert werden.
Unterstützend wirkt auch das 2x tägliche Trinken von frisch aufgebrühtem Lapacho-Tee. Einfach mal im Reformhaus danach fragen.

3) Candida - Darm-Reinigung – Kampf dem Biofilm
In den Jahren habe ich das alles ein wenig umgestellt und bin auf eine schonende, leichter anzuwendende kostengünstige Methode gestoßen. Hier arbeiten wir direkt am sogenannten Mikrofilm, der sich auf die Darmschleimhaut gelegt hat und der Candida Möglichkeiten des Unterschlupfes bietet. Mehr dazu findest Du hier …Biofilm…
Wenn Dich das interessiert, schreib mir eine kurze Nachricht mit dem Stichwort: Darm-Reinigung -Mikrofilm ... Infos anfordern
4) Candida - Darm-Reinigung
Vielleicht hast Du schon mal gegoogelt und bist über die sogenannte Colon-Hydro-Therapie gestolpert. Das ist eine geräte-unterstützte "Darm-Wäsche". Früher habe ich diese sehr aufwendige Art der Behandlung auch durchgeführt. Doch weil es für viele zu belastend ist, bin ich davon abgekommen.
Gut und praktikabel in dem Zusammenhang sind Darm-Einläufe. Viele haben davon schon einmal gehört, sind selbst aber sehr zögerlich, selbst mal einen Einlauf auszuprobieren. Ich kann Dir versichern: Es ist einfacher, als Du Dir vielleicht vorstellst. Einfach mal machen! Gerne lies noch mal ...hier... im Blog nach oder vereinbare einen Termin. Ich beantworte Deine Fragen gerne.
5) Candida – Schwermetallentgiftung – Chelat
Schwermetalle im Verdauungstrakt stehen in enger Verbindung mit einer allgemeinen Schwermetallbelastung des Körpers. Die Chelat-Therapie bietet eine wirkungsvolle Möglichkeit, diese toxischen Metalle gezielt auszuleiten.
Dabei kommen spezielle Chelatbildner zum Einsatz – chemische Substanzen, die Schwermetalle binden und die Ausscheidung der Schwermetalle über Nieren oder Darm ermöglichen. Besonders bei chronischer Schwermetallbelastung, Vergiftungen oder auch bei chronischen Beschwerden kann diese Methode helfen, den Körper zu entlasten und Schadstoffe effektiv zu entfernen.

6) Candida - Aktivierung der Verdauung
Wenn Du jeden Tag Stuhlgang hast und Dich dabei auch vollständig
entleerst, dann wirst Du auch die abgestorbenen Pilzreste auch schnell
wieder los. Das mit dem täglichen Stuhlgang ist aus meiner Erfahrung im
Umgang mit Patienten aber gar nicht so selbstverständlich.
Viele glauben noch immer, dass 3-4 mal "Entleeren" pro Woche völlig normal ist. Nein! Ist er nicht. Und gerade, wenn Du mit Darmpilzen zu tun hast, kannst Du es Dir echt nicht leisten, dass die Verdauungsreste länger als nötig in Deinem Darm verbleiben.
Deshalb:
- Trinke ausreichend stilles Wasser.
- Aktiviere Deine Verdauung zusätzlich über Kräuter-Extrakte oder verdauungsfördernde Tees.
- Nutze beim Kochen großzügig Kräuter und Gewürze. Das regt Deine Verdauungssäfte und damit auch die Gesamtverdauung an.
- Bewege Dich! Regelmäßig! Jeder Schritt, den Du tust, massiert indirekt Deinen Darm und fördert so Deine Verdauung und den Stuhlgang.
- Achte auf Deine Atmung! Eine gute und tiefe Atmung fördert die Durchblutung Deines Bauchraumes und unterstützt damit auch Deinen Darm.
- Achte auf ausreichend Ballaststoffe in der täglichen Nahrung.

7) Candida - Darmaufbau, mikrobiotische Therapie
Hier komme ich nochmal ins Spiel. Ich analysiere gemeinsam mit Dir genau Deine Ausgangssituation und stelle Dir dann ein perfekt auf Dich abgestimmtes Darm-Aufbau-Programm zusammen. Wir testen die einzelnen Präparate gezielt aus, damit es direkt zum gewünschten Therapieerfolg führt.
Mein Tipp hier: Nicht einfach irgendein Präparat im Internet bestellen. Lass Dich von mir beraten und unterstützen. dann kommst Du ohne viele Umwege ans Ziel.
8) Candida - Aktivierung des Immunsystems
Dies ist der letzte Abschnitt der Therapie. (Ein wenig überschneidet er sich mit Part 7). Hier schaue ich mit Dir noch mal ganz gezielt, an welcher Stelle wir Dein Immunsystem über den Darm neu ausrichten und stabil aufstellen.
Die Behandlung einer Candida-Belastung erfordert wirklich etwas Geduld. Ich kann Dir auf jeden Fall versprechen: Es lohnt sich, diesen Aufwand zu betreiben.
Hier kommen nun noch einige ergänzende Tipps zum Thema Candida, die sich lohnen.
Candida - Bonus-Tipps:
- Wechsele regelmäßig Deine Zahnbürste!
- Reinige Deine Zahnspangen/Schienen/Deinen Zahnersatz regelmäßig und desinfiziere diese anschließend. Nur so kannst Du sicherstellen, dass Du Dich nicht ständig reinfizierst. Gerne empfehle ich Dir eine natürlich-desinfizierende Lösung dafür.

- Besprich das Thema Candida auch mal mit Deinem Zahnarzt! Kariöse Zähne und Zahnfleischtaschen können Nistplätze für die Candida sein, die Du dann ständig wieder verschluckst und Dich dabei reinfizierst.
Erstellt am: 31.10.2021
Zuletzt bearbeitet am: 31.03.2025